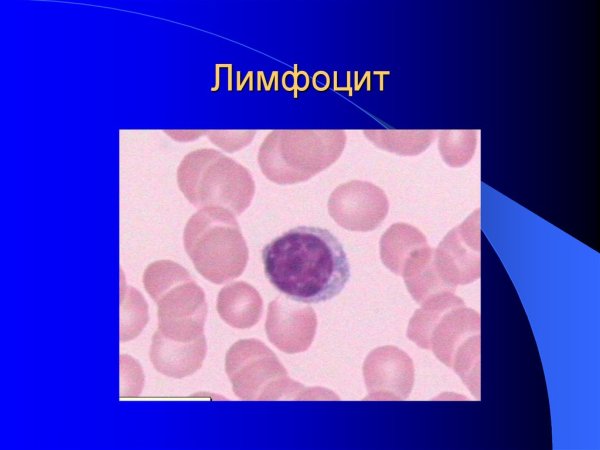
B лимфоциты
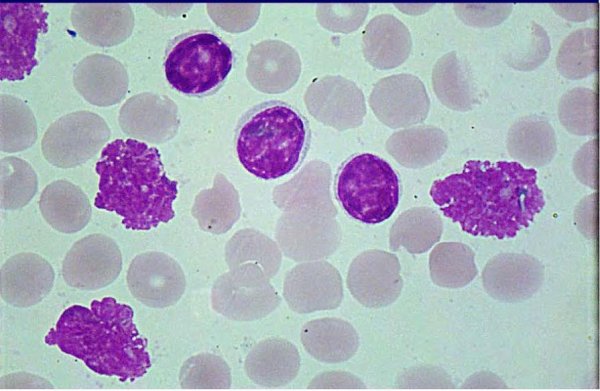
Разновидности лейкоцитов крови

Рисунок лимфоцит представляет собой графическое изображение клетки, которая является одним из важных элементов иммунной системы человека. Лимфоциты выполняют ряд функций, включая защиту организма от инфекций и опухолевых клеток, а также регуляцию иммунного ответа. На рисунке можно увидеть характерные особенности лимфоцита, такие как округлая форма клетки, наличие ядра и возможные различия в цвете, связанные с разными состояниями клетки. Рисунок лимфоцит мог бы быть полезным для медицинских учебников, научных исследований или просто для визуального представления этой важной клетки организма.
Строение лимфоцита рисунок
Тени Боткина Гумпрехта
Лимфоциты гистология рисунок
Форменные элементы кровяные клетки
Лимфоцит вектор
Т-лимфоциты рисунок
Строение т лимфоцитов гистология
B лимфоциты
Макрофаг Электронограмма
Лимфоциты электронный микроскоп
Лимфоциты гистология строение
Лимфоциты СД
Б лимфоциты строение
Б лимфоциты
Моноциты и лимфоциты рисунок
B лимфоциты строение
Строение т лимфоцитов гистология
Клетки крови моноциты лимфоциты
Схема ультрамикроскопического строения лимфоцита.
Функции клеток крови лимфоциты
Лимфоцит крови человека
Взаимодействие макрофага и лимфоцита
T И B лимфоциты
Клеточный иммунный ответ т-лимфоциты
Т-лимфоциты и в-лимфоциты
Строение т лимфоцитов
Строение клетки b-лимфоцитов
Т-лимфоциты рисунок
Б-лимфоциты иммунной системы
Т хелперы 1 иммунный ответ
Дендритные клетки схема
Взаимодействие макрофага и лимфоцита
Лимфоцит рисунок
Виды лейкоцитов нейтрофилы базофилы эозинофилы моноциты лимфоциты
Лимфоцит строение клетки
Строение т лимфоцитов гистология
Лимфоцит схематично
Механизмы противовирусного иммунитета антитела
Клетки крови моноциты лимфоциты гранулоциты
Т лимфоциты на прозрачном фоне
Строение разных видов лейкоцитов
Лейкоциты крови нейтрофил эозинофилы базофилы
Дифференцировка клеток крови схема
Схема иммунного ответа клеточный иммунитет
Клетка человека без фона
Функция NK лимфоцитов
Тельца Боткина Клейна Гумпрехта
Разновидности лейкоцитов крови
Малый лимфоцит
Смотрите онлайн или можете скачать на телефон или компьютер в хорошем качестве совешенно бесплатно. Не забывайте оставить комментарий и посмотреть другие фотографии и изображения высокого качества, например гуля рисунок и шестиугольная пирамида рисунок из раздела Рисунки

Grizly.club
Grizly.club